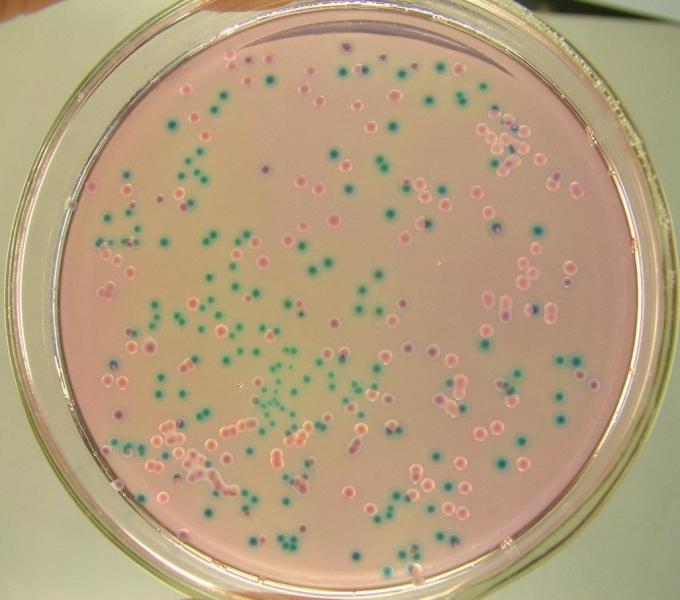
赫氏埃希菌

埃希菌属

埃希氏菌属_全景网
图片尺寸338x450
埃希氏菌属_全景网
图片尺寸670x670
放大版的大肠埃希菌
图片尺寸1080x1440
微生物学检验埃希菌属ppt
图片尺寸800x600
埃希菌属ppt课件ppt
图片尺寸920x690
微生物学课件13埃希菌属
图片尺寸800x600
埃希菌属
图片尺寸220x176
一般认为该菌群细菌可包括大肠埃希菌,柠檬酸杆菌,产气克雷伯氏菌和
图片尺寸500x333
大肠埃希菌人体共生条件致病菌
图片尺寸524x201
第9讲 消化道感染细菌ppt 第9讲 消化道感染细菌 第一节 埃希菌属
图片尺寸1170x810
大肠埃希菌的多种形态
图片尺寸1080x810
大肠埃希氏菌o157:h7/nm检验方法及结果判断
图片尺寸2048x1536
赫氏埃希菌
图片尺寸680x600
埃希氏菌属
图片尺寸150x113
埃希菌属ppt课件
图片尺寸920x690
埃希氏菌属
图片尺寸150x113
每日学习微生物大肠埃希菌
图片尺寸1080x1439
志贺毒素是一种对肠道有很强毒性的毒素,通常由志贺菌属细菌(细菌性
图片尺寸600x337
医药卫生 杆菌ppt 很全,值得学微生物的童鞋收藏 第一节 埃希菌属
图片尺寸1080x810
致泻性大肠埃希氏菌
图片尺寸370x328